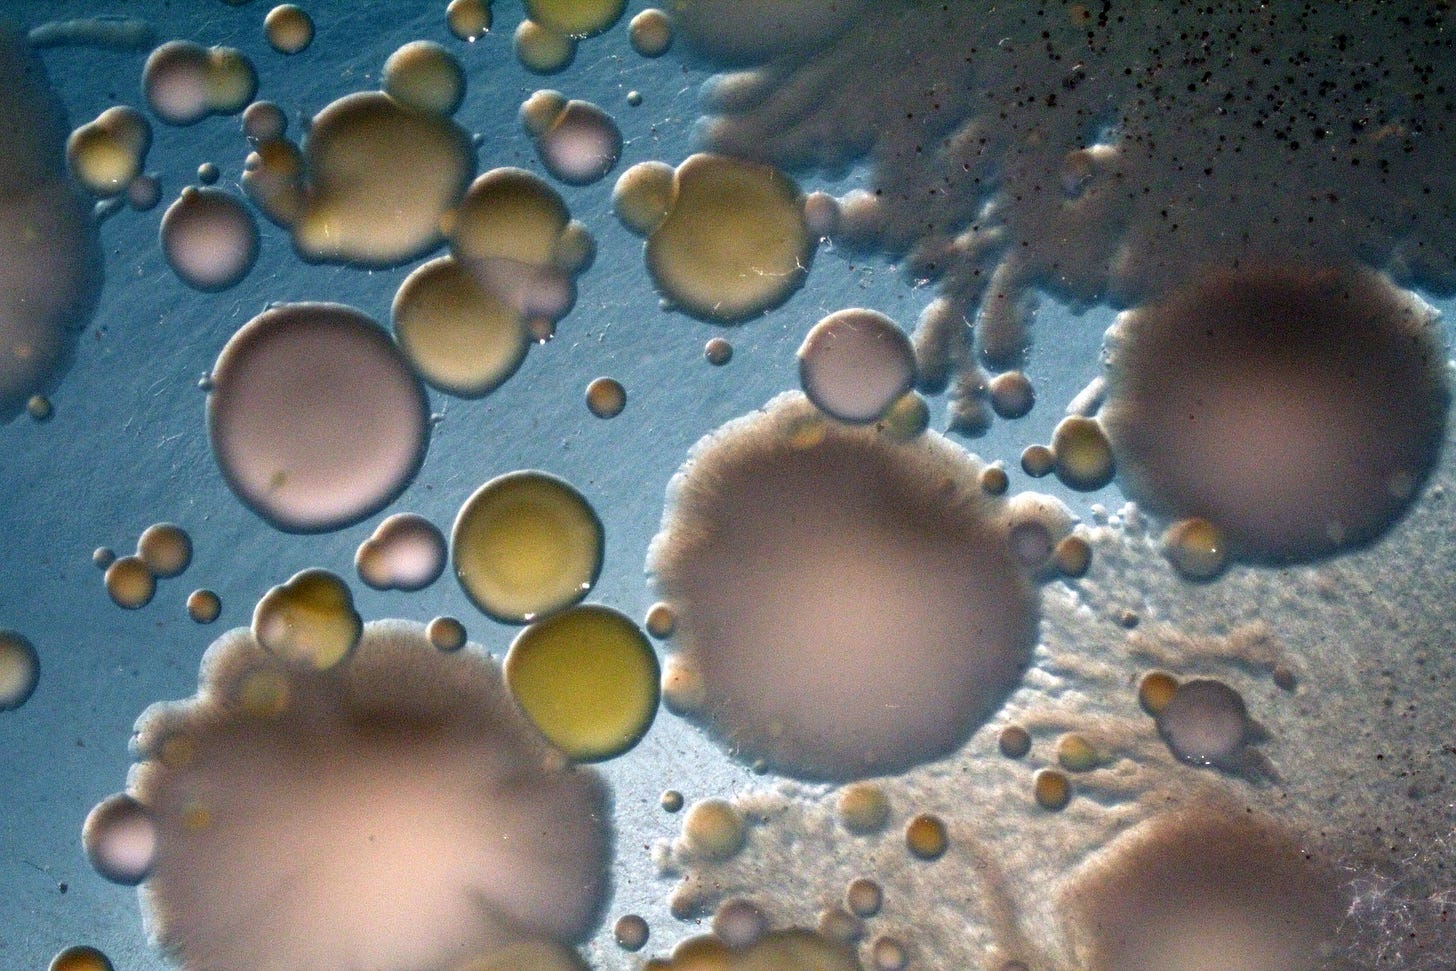

I met Rachel Dutton fifteen years ago after emailing her with the subject line “cheese + armpits.” Rachel was just starting to set up her own lab at Harvard, using cheese as a model system for studying microbial ecosystems; I was on the hunt for species of Propionibacteria, known for its ability to flavor both Swiss cheese and body odor.
Back then I was a graduate student on a unique NSF-funded grant connecting artists and synthetic biologists, paired with the brilliant smell researcher and artist Sissel Tolaas. Human body odors are also a collaboration: microbes that live on our skin feast on the oils and molecules we secrete. Particular species and ecosystems of microbes flourish, producing their own metabolites that affect our bodies and immune systems as well as unique scents. Our team noticed that the species of bacteria found on skin were also common in stinky cheeses.
We started swabbing ourselves to make our own cheese. From Rachel, we got a few Petri dishes of smelly cheese bacteria, but more vitally, we learned more about the profound connections between fermentation and our cultural and evolutionary history as human beings. We’ve been friends ever since. “Fermentation was our earliest biotechnology. It’s this amazing combination of microbial diversity and human ingenuity that came together over many thousands of years,” Rachel told me recently.
Today, Rachel is an Astera Institute resident, building a biotech startup that blends advanced microbial multi-omics, open science, and meaningful consumer health benefits, applying her 15 years of experience working with the microbial ecologies of fermented foods.
Rachel has spent her career blazing new trails for how we understand and work with microbes. When tools and model systems for studying complex microbial communities weren’t available, she built them. And when organizations and incentive systems weren’t the right fit for doing this work, she built the right teams in the right environment to do it. That’s what has led her to Astera.
The residency gives her the flexibility, resources, and community to approach the challenges of the field from a unique perspective. Rather than confine her research to the box of what can be funded by academic grants or a venture-backed startup, the residency allows her to shape from first principles the kind of organization that would best fit her goal: making the health benefits of fermented foods more accessible to all.
“Where are we going? Where are the gaps?” Rachel said. “And where are the opportunities to actually build something useful—not just uncovering new science, but to increase the impact of the science in different ways.”

Fermenting new science
Rachel’s journey with fermentation began with a slice of tomme de savoie cheese in her final year of graduate school. The raw goat milk cheese has a creamy texture and an earthy taste thanks to the microbes in its thick, bloomy rind. The postdocs and graduate students in Jon Beckwith’s microbiology lab at Harvard had gathered to enjoy wine and cheese a colleague brought back from a trip to France. As the team chatted around her, Rachel sliced into the cheese’s rustic rind and found a flash of clarity.
Rachel had spent her grad school years learning the complexities of E. coli genetics and the tools to untangle the roles of its individual genes. But her heart lay with the rich diversity of microbes in their environmental contexts, the trillions of cells in the microbiome or the thick microbial mats she had studied during a course at Woods Hole. When she looked at her slice of cheese, she didn’t just see a tasty treat, she saw a world created by and for microbes.
What species were living there? How did they work together? What kind of metabolites were they producing to keep out dangerous bacteria and create the environment to ripen the cheese into all its delicious flavors? Perhaps, like the E. coli she studied in the lab, where the relative simplicity of bacterial genetics enabled molecular biologists to understand DNA shared across the tree of life, so too might cheese offer a model to untangle the many complexities of how microbial ecosystems work.
She rushed the slice back to the lab and began isolating individual microbes from the rind to start some experiments. (You can just do things.)
“In a couple days I had these Petri dish es that smelled awful and that’s when I knew it worked,” Rachel recalled.
Cheese is far from the only culinary breeding ground for diverse microbes. Yogurt, soy sauce, sauerkraut, wine, and even chocolate are fermented. Fermentation made it possible to preserve food for longer stretches, to access more and more healthy nutrition, and to be able to plan and store food for the future. Fermentation introduced scientists to microbiology and our earliest understandings of the germ theory of disease.
This long history we have shared with microbes reflects how fundamentally entangled we are. But such complex interdependence is really hard to study in the lab, where it’s easier to look in detail at only one gene and one organism at a time. Rachel’s plan was ambitious. And her insight that cheese might be the right “model organism” for studying more complex interactions landed her a Bauer Fellowship at Harvard in 2010 and made it possible to eavesdrop on these unique ecologies in greater detail.
Navigating the (micro)ecosystem
Rachel and her team started with a broad survey of cheeses from around the world. She swabbed wheels of cheese, sequenced genomes and untangled the exchange of genes between species living in the cheese. Seeing the remarkable consistency of reproducibility of cheese communities around the world in different cheese varieties, Rachel was struck by how cheesemakers had learned to nurture remarkably robust communities in a time thousands of years before anyone knew that microbes existed.
To answer her questions about how these communities worked together, Rachel had to continuously create new tools and methods. Her lab learned how to deconstruct and reconstruct entire microbial communities; they applied genetic tools to unpack how species interact within those communities (rather than in isolation); and they crafted optimal conditions for multiple species to grow together—“in vitro cheese,” as she put it.
But the tools—and answers—she really sought began to feel out of reach. Even after years of studying fermented foods and microbial ecologies, her academic lab posed limits that wouldn’t budge. Government, corporate, and academic labs each have particular approaches to teaching, funding, and promoting science agendas. The institutions where science gets made shape the science we produce.
“Scientifically, there were problems that made me feel like I was just banging my head against the wall,” she told me. In particular, building new genetic tools for more diverse microorganisms was a foundational need for the path she was on, but difficult for both funders and students due to long timelines and high risk of failure before even getting to where you can query a hypothesis.
Those tools can open up a whole new world to exploration: “there’s just a lot more interesting biology out there in different parts of the evolutionary tree that we don’t have access to unless we build some of these tools and new ways of thinking about it,” she said.
When an opportunity came up to help build exactly these kinds of tools in an organization dedicated to opening up access to more of the tree of life, Rachel took the leap, leaving her role as a full professor at UCSD for a riskier path as a scientist at Arcadia Science. The new organization is an ambitious mix of basic science, foundational tools, and translational impact, where a new community with different resources, incentives, and motivations was coming together to explore evolutionary diversity.
Then, in 2024, she made another leap. Rachel began a residency with the young Astera Institute to build a new organization of her own.
Astera offered a different kind of environment and community for scientific exploration, and a chance to combine the translational and impact-focused perspective she developed at Arcadia with her passion for fermented foods. The residency gave Rachel the space to step back and deeply explore the landscape of fermentation, its evolutionary, molecular, and cultural histories, to see how the puzzle pieces fit together and where both gaps and new opportunities for impact lie. Rachel is now considering not just microbial ecosystems as she has for so much of her career, but also opportunities more fundamentally in science and the problems we face as humans, as people, in our food systems and in our health. She is building a new organization at Astera, one with the resources to continue to unravel the connections between microbes in fermented foods and human health.
The idea that microbes in fermented foods have a probiotic effect on health and immunity has long been recognized by science: in 1904, the Nobel Prize winning immunologist Elie Mechnikov proposed that yogurt extends longevity based on long-lived Bulgarian communities that ate it frequently. Mechnikov’s probiotic insights led to a thriving industry for yogurt more than a century ago, and the same scientific insight is behind the recent surge of probiotic supplements and trends. But microbiologists are finding that it’s often not just the microbes themselves that matter for health—it’s also the foods they eat and the metabolites they produce.
She wants to help improve access to this understanding in two ways: through publicly releasing datasets on the connections between microbial metabolites and human biology, and through developing ways for people to access the health benefits of these microbial molecules without having to dramatically increase their intake of sauerkraut.
Coevolving quickly
When we talked about what made each of her experiences work to shape the science she wanted to do, Rachel reflected that “it’s the combination of agency and community that really allows people to be their most creative and try to solve really hard problems.” You need space and resources to act on your ideas, and support to guide you when you inevitably hit snags and roadblocks along the way. “It’s all part of the journey where you can build new things. In an ideal world, we would have more opportunities for people to choose their own adventure.”
Rachel showed me how the value of agency and community holds true for both microbes and for scientists. The microbes in our fermented foods find ways to use the resources they encounter, in turn producing metabolites that dramatically shape their environment and the community of microbes around them. Those communities shape the health and biology of the humans who eat them, who learn to cultivate the environment that nurtures those microbial communities and learns from what they have to teach us.
In an essay titled “Organism and Environment” the evolutionary biologists Richard Lewontin and Richard Levins discuss the impossibility of separating the action of an individual organism from the environment it lives in. “Environments are as much the product of organisms as organisms are of environments,” they argue. “Organisms do not experience or fit into an environment, they construct it.” Fermented foods, our bodies, and the world, are all shaped by a reciprocal codetermination of individuals and their environment.
We have co-evolved with the microbes in our bodies and in our fermented foods. We learned to care for and crave microbes that helped nourish and protect us in turn. Our foods and bodies share a litany of close cousins, like the Propionibacteria in armpits and Swiss cheese. They have even shaped our genes. Humans and our close relatives have evolved uncommon tolerance and affinity for products of fermentation like alcohol and acidic flavors. More recently, scientists have begun to uncover even deeper molecular interactions between the microbial metabolites produced in high concentrations in fermented foods like sauerkraut and specialized immune receptors and turn on anti-inflammatory pathways and promote long-term health. These deep molecular connections are at the core of Rachel’s research today.

Scientists are likewise shaped by their environment, the labs and communities that train them, and the resources and incentives that shape their work. They shape those communities and those opportunities and resources in turn. They create new niches, new disciplines—like fermentation ecology—and ways of studying; they build new tools, teams, and generational wisdom.
For Rachel, it’s those unique communities that cultivate agency that lead to great science. “I feel very lucky to be able to have these opportunities,” she said. “But especially to have people who helped me build the confidence to be able to say—What do you want to do? Now go figure out how to do it, go solve the problems that you wanna solve.”